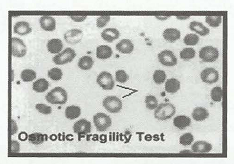

النبات

مواضيع عامة في علم النبات

الجذور - السيقان - الأوراق

النباتات الوعائية واللاوعائية

البذور (مغطاة البذور - عاريات البذور)

الطحالب

النباتات الطبية


الحيوان

مواضيع عامة في علم الحيوان

علم التشريح

التنوع الإحيائي

البايلوجيا الخلوية


الأحياء المجهرية

البكتيريا

الفطريات

الطفيليات

الفايروسات


علم الأمراض

الاورام

الامراض الوراثية

الامراض المناعية

الامراض المدارية

اضطرابات الدورة الدموية

مواضيع عامة في علم الامراض

الحشرات


التقانة الإحيائية

مواضيع عامة في التقانة الإحيائية


التقنية الحيوية المكروبية

التقنية الحيوية والميكروبات

الفعاليات الحيوية

وراثة الاحياء المجهرية

تصنيف الاحياء المجهرية

الاحياء المجهرية في الطبيعة

أيض الاجهاد

التقنية الحيوية والبيئة

التقنية الحيوية والطب

التقنية الحيوية والزراعة

التقنية الحيوية والصناعة

التقنية الحيوية والطاقة

البحار والطحالب الصغيرة

عزل البروتين

هندسة الجينات


التقنية الحياتية النانوية

مفاهيم التقنية الحيوية النانوية

التراكيب النانوية والمجاهر المستخدمة في رؤيتها

تصنيع وتخليق المواد النانوية

تطبيقات التقنية النانوية والحيوية النانوية

الرقائق والمتحسسات الحيوية

المصفوفات المجهرية وحاسوب الدنا

اللقاحات

البيئة والتلوث


علم الأجنة

اعضاء التكاثر وتشكل الاعراس

الاخصاب

التشطر

العصيبة وتشكل الجسيدات

تشكل اللواحق الجنينية

تكون المعيدة وظهور الطبقات الجنينية

مقدمة لعلم الاجنة


الأحياء الجزيئي

مواضيع عامة في الاحياء الجزيئي


علم وظائف الأعضاء


الغدد

مواضيع عامة في الغدد

الغدد الصم و هرموناتها

الجسم تحت السريري

الغدة النخامية

الغدة الكظرية

الغدة التناسلية

الغدة الدرقية والجار الدرقية

الغدة البنكرياسية

الغدة الصنوبرية

مواضيع عامة في علم وظائف الاعضاء

الخلية الحيوانية

الجهاز العصبي

أعضاء الحس

الجهاز العضلي

السوائل الجسمية

الجهاز الدوري والليمف

الجهاز التنفسي

الجهاز الهضمي

الجهاز البولي


المضادات الميكروبية

مواضيع عامة في المضادات الميكروبية

مضادات البكتيريا

مضادات الفطريات

مضادات الطفيليات

مضادات الفايروسات

علم الخلية

الوراثة

الأحياء العامة

المناعة

التحليلات المرضية

الكيمياء الحيوية

مواضيع متنوعة أخرى

الانزيمات
تحاليل فقر الدم (الانيميا Anemia)
المؤلف:
د. حنين ولى و د. مصري خليفة
المصدر:
التحاليل الطبية والأشعة والفحوصات الإكلينيكية
الجزء والصفحة:
1873
تحاليل فقر الدم (الانيميا Anemia)
اختبار الكشف عن الخلايا الشبكية (Reticulocyte Cells)


الهدف من اجراء الاختبار :
يستخدم هذا الاختبار للكشف عن مدى سلامة النخاع العظمي .(Bone Marrow)
- الامراض النزيفية (الحالات الشديدة منها) .
- تشخيص الحالات المرضية مثل مرض فقر الدم (الانيميا) ، ويتم اجراء هذا التحليل أيضا لمعرفة مدى فعالية علاج مرض فقر الدم وذلك عن طريق عد الخلايا الشبكية ومعرفة نسبتها .
اختبار الكشف عن الخلايا المنجلية (Sickling Test)
الهدف من اجراء الاختبار :
يحدد هذا الاختبار وجود فقر الدم المنجلي او عدمه ، ومرض فقر الدم المنجلي هو حالة خاصة من حالات مرض فقر الدم (الانيميا) ، والتي تظهر فيها كرات الدم الحمراء على شكل المنجل (الهلال) ، وذلك نظرا لوجود كمية من الهيموجلوبين غير الطبيعي التي تؤدي الى ترسيبه على شكل الكريستال في حالة نقص الاكسجين في الدم مما يعطي كرات الدم شكل المنجل .
يرافق مرض فقر الدم المنجلي دائما حصول :

- نقص في تركيز الهيموجلوبين يصل الى 6 جم لكل 100مل .
- زيادة في عدد الخلايا الشبكية Reticulocyte Cell يصل ما بين 15 الى 40 % في الدم .
اختبار الفصل الكهربائي للهيموجلوبين Haemoglobin Electrophoresis

الهدف من اجراء الاختبار :
التعرف على الأنواع المختلفة للهيموجلوبين حيث تختلف هذه الأنواع باختلاف سلاسل الجلوبين المكونة له .
اختبار هشاشة كرات الدم الحمراء (Osmotic Fragility tes= O .F .T)
الهدف من اجراء الاختبار :
معرفة زيادة هشاشة كرات الدم الحمراء ومعرفة مدى زيادة تكسيرها في تركيزات مرتفعة نسبيا من المحلول الملحي العادي .
أختبار صبغة الحديد Iron stain
أختبار صبغة الحديد Iron stain


الهدف من اجراء الاختبار :
هو الكشف عن وجود عنصر الحديد في الانسجة بما فيها الكبد والنخاع العظمى وفي ترسيب البول ، حيث يلاحظ الزيادة او النقص في تركيز الحديد في هذه الانسجة حسب الحالات المرضية التالية :
1) يلاحظ نقص الحديد في فقر الدم الناتج عن نقص الحديد .(Iron Deficiency Anemia)
2) كما تلاحظ زيادة تركيز الحديد في الانسجة كما في الحالات التالية :
- مرض انيميا البحر الأبيض المتوسط Thalassemia)) نتيجة لنقل الدم المتكرر للمريض .
- في حالة مرض (Hemochromatosis)
 الاكثر قراءة في التحليلات المرضية
الاكثر قراءة في التحليلات المرضية
 اخر الاخبار
اخر الاخبار
اخبار العتبة العباسية المقدسة

الآخبار الصحية















 قسم الشؤون الفكرية يصدر كتاباً يوثق تاريخ السدانة في العتبة العباسية المقدسة
قسم الشؤون الفكرية يصدر كتاباً يوثق تاريخ السدانة في العتبة العباسية المقدسة "المهمة".. إصدار قصصي يوثّق القصص الفائزة في مسابقة فتوى الدفاع المقدسة للقصة القصيرة
"المهمة".. إصدار قصصي يوثّق القصص الفائزة في مسابقة فتوى الدفاع المقدسة للقصة القصيرة (نوافذ).. إصدار أدبي يوثق القصص الفائزة في مسابقة الإمام العسكري (عليه السلام)
(نوافذ).. إصدار أدبي يوثق القصص الفائزة في مسابقة الإمام العسكري (عليه السلام)


















